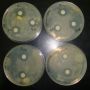
14 10 17 noticia caracterizacion pesticida

Avances del Proyecto
Estás aquí: Inicio Avances del Proyecto

En el Centro Tecnológico Agroalimentario de Extremadura CTAEX, ha tenido lugar hoy una Jornada de Difusión del Proyecto LIFE+/ENV/ES000613 SAVECROPS Pesticidas polivalentes obtenidos a partir de residuos agroalimentarios locales, cuyo objetivo principal es obtener principios activos con capacidad biocida de los residuos de determinados cultivos (ajo, cebolla, brócoli, etc. ) para ser utilizados como pesticidas naturales para el control de un amplio número de patógenos vegetales en los tres cultivos más importantes de la región: tomate de industria, olivo y vid.
Leer más
Las aceitunas procedentes de los diversos tratamientos se han procesado en la Planta Piloto de CTAEX. Tras la limpieza de las aceitunas, se han determinado la textura y el color de los frutos de cada tratamiento pesticida.
Leer más
Se han cosechado las aceitunas de los diferentes tratamientos ensayados en la parcela de ensayo del olivar, en Montijo.
Leer másInvestigadores portugueses de un proyecto de germoplasma de poleo y de cilantro visitan las instalaciones de CTAEX

El viernes 24 de octubre, un grupo de investigadores del Instituto Politécnico de Portalegre y productores de plantas aromáticas y medicinales de Portugal, visitaron el Centro Tecnológico Agroalimentario "Extremadura", en el marco de las II Jornadas de divulgación del proyecto PRODER 18660 Colheita, conservação e valorização de germoplasma de poejos e coentros no Alentejo.
Leer más
Se han finalizado los ensayos de estabilidad del producto biocida elaborado a base de residuos de suero láctico y extracto de ajo (Acción B2 del proyecto), con el objetivo de evaluar la influencia de diversas condiciones medioambientales en la eficacia del producto.
Leer más